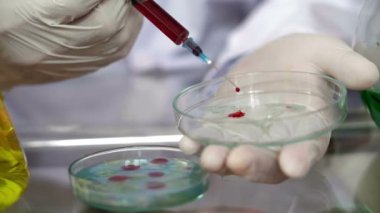
LB agar ortamına şırınga ile pipetleme hücre kültür örnekleri ve serum kapatın
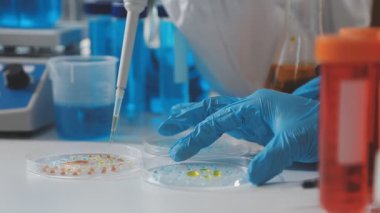
Bir deney tüpü üzerinde çalışan bilim adamının yakın çekimi.

İhlal Bildirim Formu
En Çok Aranan Kelimeler
donanımİlaç.Sağlık hizmetleriTıbbiEldivenlersanayiHastanemesleğiTest etGörevkültürKimyasalDeneyLaboratuvarBilimmeslekvirüsŞırıngatezgaharaştırmaanalizbiyoklinikBiyoteknoloji.bilim adamıBakterilerDNAMikrobiyolojiaşılamakaşılamaimmanuel kantPetri ÇanağıBenzer İçerikler